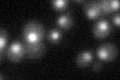
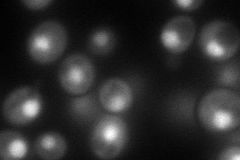
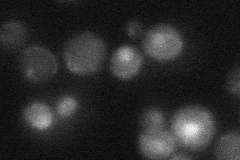

View description
Poly(A+) RNA-binding protein, involved in the export of mRNAs from the nucleus to the cytoplasm; similar to Hrb1p and Npl3p; also binds single-stranded telomeric repeat sequence in vitro
Localization:
Intensity:
Fold change:
Significance:
-
C’ GFP library in SD
nucleus30.52 -
N' NOP1pr-GFP in SD
nucleus114.17 -
N' TEF2pr-mCherry in SD

nucleus124.702 -
N' NATIVEpr-GFP in SD
below threshold20.7962 -
N' TEF2pr-VC and Cyto-VN in SD

#N/A0 -
C’ GFP library in SD+DTT

nucleus27.090.88No -
C’ GFP library in SD+H2O2

nucleus32.911.07No -
C’ GFP library in Starvation Media

nucleus16.770.54Yes -
C’ GFP library on the background of Pup2-DaMP

nucleus -
C’ GFP library on the background of CCT mutant

nucleus32.21761.05531No
